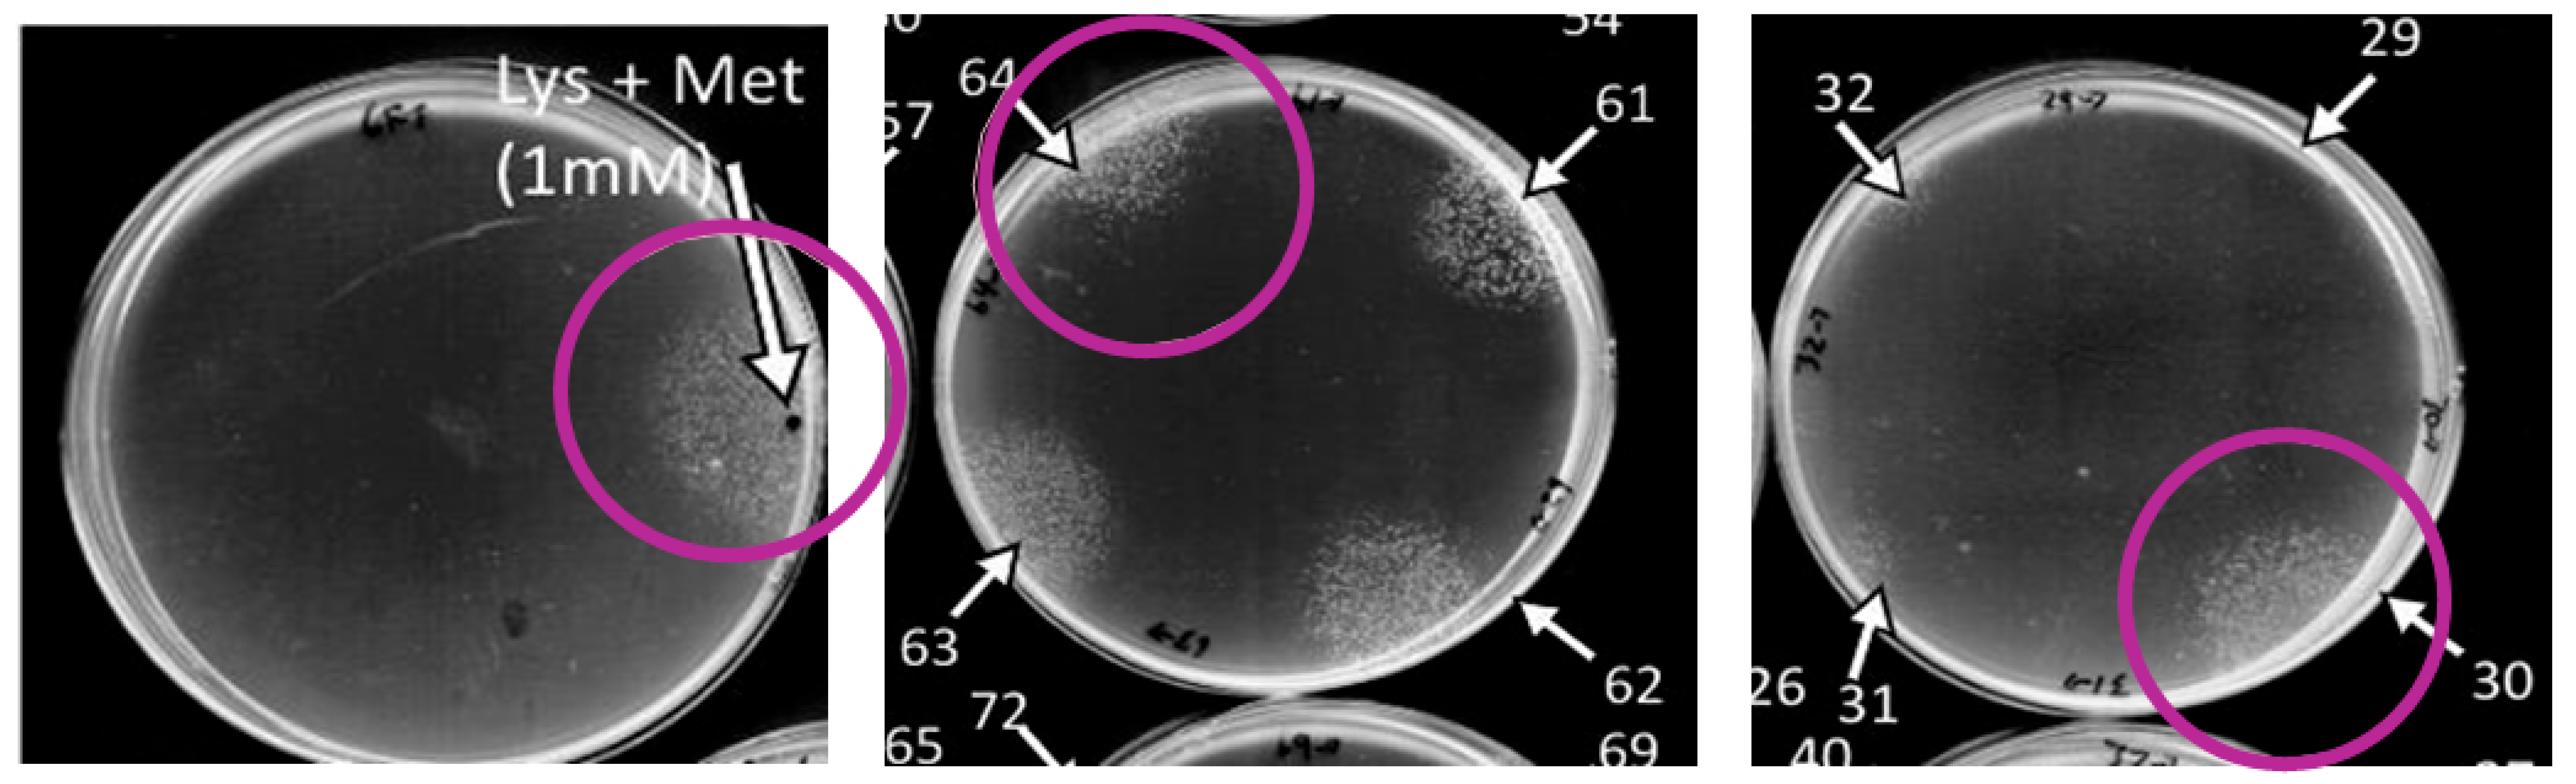

In Vitro Reversal of Escherichia coli Quiescence by Catechol-Containing Polyphenols and Phenolic Acids Across Multiple Strains
Abstract
1. Introduction
2. Materials and Methods
2.1. Chemicals
2.2. General Experimental Procedures
2.3. Preparation of Plant Extracts
2.4. Bacterial Strains and Cultivation
2.5. Molecular Network Analysis of Active Plant Extracts
2.6. In Vitro Quiescence Inhibition Assay
2.7. Chrome Azurol S (CAS) Assay
3. Results and Discussion
3.1. Initial Extract Screening: Aqueous and Organic Medicinal Plant Extracts Exhibited Quiescence-Reversal Activity in CFT073 Assay
3.2. GNPS Networking Identified Polyphenols and Phenolic Acids as Abundant in the Aerial Extracts
3.3. Structure Activity Relationships: Pure Compound Screen Identifies Hydroxylated Compounds as Active on the CFT073 Assay
3.4. Quiescence-Reversal Assays in Additional Strains
3.5. Iron-Binding Activities of Test Compounds
4. Conclusions
Supplementary Materials
Author Contributions
Funding
Institutional Review Board Statement
Informed Consent Statement
Data Availability Statement
Acknowledgments
Conflicts of Interest
References
- Ventola, C.L. The antibiotic resistance crisis Part 1. J. Clin. Pharm. Ther. 2015, 40, 277–283. [Google Scholar]
- Sun, J.; Deering, R.W.; Peng, Z.; Najia, L.; Khoo, C.; Cohen, P.S.; Seeram, N.P.; Rowley, D.C. Pectic oligosaccharides from cranberry prevent quiescence and persistence in the uropathogenic Escherichia coli CFT073. Sci. Rep. 2019, 9, 19590. [Google Scholar] [CrossRef]
- Flores-Mireles, A.L.; Walker, J.N.; Caparon, M.; Hultgren, S.J. Urinary tract infections: Epidemiology, mechanisms of infection and treatment options. Nat. Rev. Microbiol. 2015, 13, 269–284. [Google Scholar] [CrossRef]
- Nuutinen, M.; Uhari, M. Recurrence and follow-up after urinary tract infection under the age of 1 year old. Pediatr. Nephrol. 2001, 16, 69–72. [Google Scholar] [CrossRef] [PubMed]
- Leatham-Jensen, M.P.; Mokszycki, M.E.; Rowley, D.C.; Deering, R.; Camberg, J.L.; Sokurenko, E.V.; Tchesnokova, V.L.; Frimodt-Møller, J.; Krogfelt, K.A.; Leth Nielsen, K.; et al. Uropathogenic Escherichia coli metabolite-dependent quiescence and persistence may explain antibiotic tolerance during urinary tract infection. mSphere 2016, 1, e00055-15. [Google Scholar] [CrossRef]
- Mysorekar, I.U.; Hultgren, S.J. Mechanisms of uropathogenic Escherichia coli persistence and eradication from the urinary tract. Proc. Natl. Acad. Sci. USA 2006, 103, 14170–14188. [Google Scholar] [CrossRef]
- Silverman, J.A.; Schreiber, H.L.; Hooton, T.M.; Hultgren, S.J. From physiology to pharmacy: Developments in the pathogenesis and treatment of recurrent urinary tract infections. Curr. Urol. Rep. 2013, 14, 448–456. [Google Scholar] [CrossRef]
- Rosen, D.A.; Hooton, T.M.; Stamm, W.E.; Humphrey, P.A.; Hultgren, S.J. Detection of intracellular bacterial communities in human urinary tract infection. PLoS Med. 2007, 4, e329. [Google Scholar] [CrossRef]
- DiBiasio, E.C.; Ranson, H.J.; Johnson, J.R.; Rowley, D.C.; Cohen, P.S.; Camberg, J.L. Peptidoglycan sensing prevents quiescence and promotes quorum-independent colony growth of uropathogenic Escherichia coli. J. Bacteriol. 2020, 202, e00157-20. [Google Scholar] [CrossRef]
- Rossiter, S.E.; Fletcher, M.H.; Wuest, W.M. Natural products as platforms to overcome antibiotic resistance. Chem. Rev. 2017, 117, 12415–12474. [Google Scholar] [CrossRef] [PubMed]
- Fazly, B.S.; Khameneh, B.; Zahedian, M.R.; Hosseinzadeh, H. In vitro evaluation of antibacterial activity of verbascoside, lemon verbena extract and caffeine in combination with gentamicin against drug-resistant Staphylococcus aureus and Escherichia coli clinical isolates. Avicenna J. Phytomed. 2018, 8, 246–253. [Google Scholar]
- Kirk, R.D.; Carro, M.A.; Wu, C.; Jamal, M.; Wharton, A.M.; Goldstein, D.G.; Rosario, M.E.; Gallucci, G.M.; Zhao, Y.; Leibovitz, E.; et al. Integrating natural product chemistry workflows into medicinal chemistry laboratory training: Building the PRISM library and cultivating independent research. J. Chem. Educ. 2020, 98, 410–415. [Google Scholar] [CrossRef]
- Alhafez, M.; Kheder, F.; Alijoubbeh, M. Synthesis, antioxidant activity and antibacterial study of EGCG complexes with iron(III) ions. Results Chem. 2022, 4, 100638. [Google Scholar] [CrossRef]
- Wang, M.; Carver, J.J.; Phelan, V.V.; Sanchez, L.M.; Garg, N.; Peng, Y.; Nguyen, D.D.; Watrous, J.; Kapono, C.A.; Luzzatto-Knaan, T.; et al. Sharing and community curation of mass spectrometry data with Global Natural Products Social Molecular Networking. Nat. Biotechnol. 2016, 34, 828–837. [Google Scholar] [CrossRef]
- Bijlsma, J.; de Bruijn, W.J.C.; Hageman, J.A.; Goos, P.; Velikov, K.P.; Vincken, J.-P. Revealing the main factors and two-way interactions contributing to food discolouration caused by iron-catechol complexation. Sci. Rep. 2020, 10, 8288. [Google Scholar] [CrossRef] [PubMed]
- Rogers, H.J. Iron-binding catechols and virulence in Escherichia coli. Infect. Immun. 1973, 7, 445–456. [Google Scholar] [CrossRef]
- Regner, A.; Szepannek, N.; Wiederstein, M.; Fakhimahmadi, A.; Paciosis, L.F.; Blokhuis, B.R.; Redegeld, F.A.; Hofstetter, G.; Dvorak, Z.; Jensen-Jarolim, E.; et al. Binding to iron quercetin complexes increases the antioxidant capacity of the major birch pollen allergen Bet v 1 and reduces its allergenicity. Antioxidants 2020, 12, 42. [Google Scholar] [CrossRef] [PubMed]
- Zhou, Y.; Zhou, Z.; Jin, L.; Peng, Y.; Tang, J.; Wang, A.; Zhou, M.; Li, Y.; Zheng, L.; Huang, Y. The effects and mechanisms of aqueous Persicaria capitata extract on uropathogenic Escherichia coli adhesion. Phytomedicine 2025, 139, 156515. [Google Scholar] [CrossRef]
- Maisto, M.; Iannuzzo, F.; Novellino, E.; Schiano, E.; Piccolo, V.; Tenore, G.C. Natural polyphenols for prevention and treatment of urinary tract infections. Int. J. Mol. Sci. 2023, 24, 3277. [Google Scholar] [CrossRef]
- van Duynhoven, J.; Vaughan, E.E.; Jacobs, D.M.A.; Kemperman, R.; van Velzen, E.J.J.; Gross, G.; Roger, L.C.; Possemiers, S.; Smilde, A.K.; Doré, J.; et al. Metabolic fate of polyphenols in the human superorganism. Proc. Natl. Acad. Sci. USA 2011, 108 (Suppl. 1), 4531–4538. [Google Scholar] [CrossRef]
- Coyle, C.H.; Philips, B.J.; Morrisroe, S.N.; Chancellor, M.B.; Yoshimura, N. Antioxidant effects of green tea and its polyphenols on bladder cells. Life Sci. 2008, 83, 12–18. [Google Scholar] [CrossRef]
- González de Llano, D.; Roldán, M.; Taladrid, D.; Relaño de la Guía, E.; Moreno-Arribas, M.V.; Bartolomé, B. Cranberry polyphenols and prevention against urinary tract infections: New findings related to the integrity and functionality of intestinal and urinary barriers. J. Agric. Food Chem. 2024, 72, 10328–10338. [Google Scholar] [CrossRef] [PubMed]
- Luscher, A.; Moynié, L.; Auguste, P.S.; Bumann, D.; Mazza, A.; Abergel, R.J.; Schalk, I.J. Plant-derived catechols are substrates of TonB-dependent transporters and sensitize Pseudomonas aeruginosa to siderophore-drug conjugates. mBio 2022, 13, e01498-22. [Google Scholar] [CrossRef] [PubMed]
- Morrison, J.J.; Madden, E.K.; Banas, D.A.; DiBiasio, E.C.; Hansen, M.; Krogfelt, K.A.; Rowley, D.C.; Cohen, P.S.; Camberg, J.L. Metabolic flux regulates growth transitions and antibiotic tolerance in uropathogenic Escherichia coli. J. Bacteriol. 2024, 206, e00162-24. [Google Scholar] [CrossRef] [PubMed]

Disclaimer/Publisher’s Note: The statements, opinions and data contained in all publications are solely those of the individual author(s) and contributor(s) and not of MDPI and/or the editor(s). MDPI and/or the editor(s) disclaim responsibility for any injury to people or property resulting from any ideas, methods, instructions or products referred to in the content. |
© 2025 by the authors. Licensee MDPI, Basel, Switzerland. This article is an open access article distributed under the terms and conditions of the Creative Commons Attribution (CC BY) license (https://creativecommons.org/licenses/by/4.0/).
Share and Cite
Jouaneh, T.M.M.; Morrison, J.J.; Luthern, A.C.; Kirk, R.D.; Camberg, J.L.; Bertin, M.J. In Vitro Reversal of Escherichia coli Quiescence by Catechol-Containing Polyphenols and Phenolic Acids Across Multiple Strains. Nutraceuticals 2025, 5, 29. https://doi.org/10.3390/nutraceuticals5040029
Jouaneh TMM, Morrison JJ, Luthern AC, Kirk RD, Camberg JL, Bertin MJ. In Vitro Reversal of Escherichia coli Quiescence by Catechol-Containing Polyphenols and Phenolic Acids Across Multiple Strains. Nutraceuticals. 2025; 5(4):29. https://doi.org/10.3390/nutraceuticals5040029
Chicago/Turabian StyleJouaneh, Terra Marie M., Josiah J. Morrison, Abigail C. Luthern, Riley D. Kirk, Jodi L. Camberg, and Matthew J. Bertin. 2025. "In Vitro Reversal of Escherichia coli Quiescence by Catechol-Containing Polyphenols and Phenolic Acids Across Multiple Strains" Nutraceuticals 5, no. 4: 29. https://doi.org/10.3390/nutraceuticals5040029
APA StyleJouaneh, T. M. M., Morrison, J. J., Luthern, A. C., Kirk, R. D., Camberg, J. L., & Bertin, M. J. (2025). In Vitro Reversal of Escherichia coli Quiescence by Catechol-Containing Polyphenols and Phenolic Acids Across Multiple Strains. Nutraceuticals, 5(4), 29. https://doi.org/10.3390/nutraceuticals5040029

